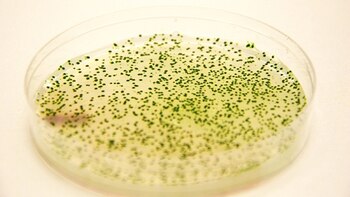
La bacteria heredó su nombre

"Viajero audaz", es el nombre de la nueva superbacteria que microbiólogos rusos lograron aislar y detectaron que es capaz de sobrevivir en el espacio.
Y es que científicos de la Universidad Estatal de Tomsk hicieron historia con la bacteria Desulforudis audaxviator, capaz de vivir sin luz ni oxígeno, por lo que podría sobrevivir en el espacio o en planetas como Marte.
"El enorme interés se debe a la capacidad del microorganismo para obtener energía en ausencia de oxígeno y en oscuridad total. Teóricamente puede demostrar que la vida en otro planeta es posible, por ejemplo en Marte", remarcó en un comunicado la universidad.

La bacteria, cuyo nombre en latín significa "viajero audaz", es conocida por la comunidad científica desde hace más de diez años, cuando su rastro fue detectados en las profundidades de la Tierra. Según la jefa de cátedra de Fisiología de las plantas de dicha universidad, Olga Karnachuk, el rastro genético de esta bacteria fue descubierto en el agua de una mina de oro de Sudáfrica hace más de una década.
"Las muestras tomadas se realizaron a profundidades entre 1,5 y 3 kilómetros. Hasta hace poco se consideraba que la vida en estas condiciones era imposible, porque sin luz no existe la fotosíntesis, base de todas las cadenas alimenticias. Pero resulta que esta suposición era errónea", explicó la experta en su trabajo.

"Las muestras tomadas se realizaron a profundidades entre 1,5 y 3 kilómetros. Hasta hace poco se consideraba que la vida en estas condiciones era imposible, porque sin luz no existe la fotosíntesis, base de todas las cadenas alimenticias. Pero resulta que esta suposición era errónea", explicó la experta en su trabajo.
El descubrimiento de las fumarolas hidrotermales en el fondo del océano ya había puesto en duda que la fotosíntesis fuese imprescindible para la vida, puesto que en torno a ellas habitan colonias enteras de criaturas que no requieren de la luz para sobrevivir.
A diferencia de ellas, la Desulforudis audaxviator subsiste en total aislamiento, ya que junto a su ADN no fueron hallados restos de otros seres vivos. Los científicos explicaban la dificultad de "atrapar" a la bacteria con la teoría de que esta se dividía una vez cada mil años, pero los científicos rusos establecieron que se divide una vez cada 28 horas.

Los microbiólogos también descubrieron que la bacteria se alimenta prácticamente de todo, incluyendo azúcar y alcohol, aunque "prefiere" el hidrógeno, más energético, y que es inmune al oxígeno, supuestamente letal para los habitantes de las profundidades.
Otro detalle curioso fue el descubrimiento de los orgánulos que le permiten viajar: se trata de vacuolas gaseosas parecidas a la vejiga natatoria de los peces. Sin embargo, hasta ahora no se ha podido establecer cómo se trasladan por las profundidades terrestres.
Qué significa este descubrimiento
El doctor en Biología, Federico Prada, director de las Licenciaturas en Biotecnología y Bioinformática en Universidad Argentina de la Empresa (UADE) explicó a Infobae las características de este descubrimiento.
"Se había descubierto a raíz de la evolución de la genómica. Se sabía que existía, pero no había podido ser rastreada en los últimos 10 años. Antes, se había hallado el ADN pero no la bacteria, lo que resulta impresionante", explicó Prada.

Y agregó: "Ahora que fue hallada y estudiada, se pudo saber ciertas características de su genoma, a pesar de no hallarla viva. Se supo qué propiedades tiene y lo más importante: se la caracterizó como un extremófilo, es decir un organismo con afinidad a las condiciones extremas".
"La bacteria no necesita oxígeno vivir, es decir para metabolizar. Pero tampoco le es dañino, como le suele ocurrir a otro tipo de bacterias. Hace su propio metabilismo y utiliza el hidrógeno como parte de su cadena energética para vivir", indicó.
Pero el experto en biología, realizó un cuestionamiento preciso: "Que no necesite oxígeno para vivir no significa que pueda vivir en el espacio. Sí podría vivir tal vez en otro planeta como Marte. Pero las condiciones en el espacio exterior son muy duras, extremas. La bacteria allí está sometida a una falta de baja presión y a condiciones de vacío extremas. Al igual que a una alta radiación".

Una cosa fascinante que describió el científico de la UADE es que el organismo fue hallado en una cueva de 3 kilometros de profundidad en un lugar en el que logró formar un ecosistema de una sola especie. "El ecosistema es la misma bacteria. No comparte espacio con otra similar u otro organismo. Es increíble", explicó Prada.
Respecto a los riesgos que esta bacteria podría tener para el ser humano, Prada afirmó que "no hay evidencia de que sea peligrosa para la salud humana".
Prada concluyó que "a raíz de estos descubrimentos podrían surgir nuevas profesiones a futuro. Aquellas que todavía no se han desarrollado pero que sí serán clave en un futuro no muy lejano, cuando el hombre comience a habitar otros mundos. Carreras como Biotecnología especializada en exobiología, por ejemplo, nos ayudarían a conocer este tipo de bacterias que pueden sobrevivir en otros mundos y coexistir con el hombre. Estamos acostumbrados a estudiar nuestra naturaleza. Pero no más allá de nuestra frontera celeste".
Una bacteria con nombre
La bacteria heredó su nombre del libro de Julio Verne "Viaje al centro de la Tierra", donde aparece el texto "Descende, audax viator, et terrestre centrum attinges" (Desciente, audaz viajero, y alcanza el centro de la Tierra".
"Hasta hace poco se consideraba que la vida en esas condiciones era imposible ya que sin luz no se produce la fotosíntesis, un proceso fundamental en todas las cadenas alimenticias. Pero resultó que esa hipótesis era errónea", enfatizó la científica Karnachuk.
En la universidad señalaron que tras la publicación de un artículo de los estudiosos norteamericanos en la revista Science, científicos de diversos países empezaron a buscar la bacteria. Su ADN fue identificado en Finlandia y Estados Unidos, pero el propio microorganismo no fue hallado.
Los investigadores rusos fueron los primeros en descubrir el Desulforudis audaxviator en aguas subterráneas de una fuente termal situada en los bosques siberianos al norte de la ciudad de Tomsk.
Desulforudis audaxviator es una de las bacterias más antiguas que habitan nuestro planeta y se caracteriza por sobrevivir sin oxígeno y obtener energía a partir de sulfatos y la oxidación del hidrógeno o compuestos orgánicos.
SEGUÍ LEYENDO:
Identifican una bacteria que podría tener un papel clave en el desarrollo del Alzheimer
Vincularon el mal de Alzheimer con una bacteria que causa una enfermedad dental común
Últimas Noticias
Más de la mitad de los profesores y sanitarios están ‘quemados’: el desgaste profesional es estructural en Sanidad y Educación
La carga horaria excesiva y la inestabilidad laboral provocan un desgaste emocional elevado en estos trabajadores esenciales

Francia alerta de un fármaco para la angina de pecho que está provocando efectos secundarios graves: la situación del medicamento en España
Nicorandil es un principio activo recetado “como último recurso” para pacientes con esta cardiopatía

La actriz Mariana Gómez anunció en una emotiva presentación en vivo que será madre: “Lo que algún día soñé”
La artista paisa compartió la noticia de su embarazo en el escenario, recibió aplausos y mensajes de apoyo de sus colegas y seguidores, y generó expectativa en redes sociales por la identidad de su pareja

Javier Rabanal quedó habilitado: Comisión de Apelaciones revocó sanción y dirigirá en Universitario vs Comerciantes Unidos
La comisión dio marcha atrás y dejó sin efecto la suspensión de 4 fechas tras incidente con hinchas de Sporting Cristal en el estadio Alberto Gallardo. Conoce los detalles

La Unión Sindical Obrera planea una huelga si Ricardo Roa no renuncia a la presidencia de Ecopetrol: “Podríamos convocarla a nivel nacional”
El presidente del sindicato, Martín Ravelo, señaló que están abiertos a negociar con la junta directiva de la empresa petrolera




